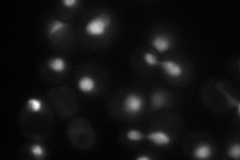
YNL167C
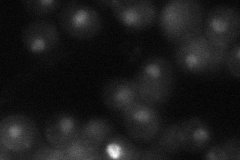
YNL167C
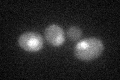
YNL167C

View description
Basic leucine zipper (bZIP) transcription factor of the ATF/CREB family, forms a complex with Tup1p and Ssn6p to both activate and repress transcription; cytosolic and nuclear protein involved in osmotic and oxidative stress responses
Localization:
Intensity:
Fold change:
Significance:
-
C’ GFP library in SD

nucleus21.33 -
N' NOP1pr-GFP in SD
nucleus60.7619 -
N' TEF2pr-mCherry in SD

missing0 -
N' NATIVEpr-GFP in SD
nucleus26.0125 -
N' TEF2pr-VC and Cyto-VN in SD

nucleus40.4705 -
C’ GFP library in SD+DTT

nucleus22.261.04No -
C’ GFP library in SD+H2O2
nucleus21.230.99No -
C’ GFP library in Starvation Media

nucleus18.860.88No -
C’ GFP library on the background of Pup2-DaMP

nucleus -
C’ GFP library on the background of CCT mutant

nucleus25.25681.18361No
